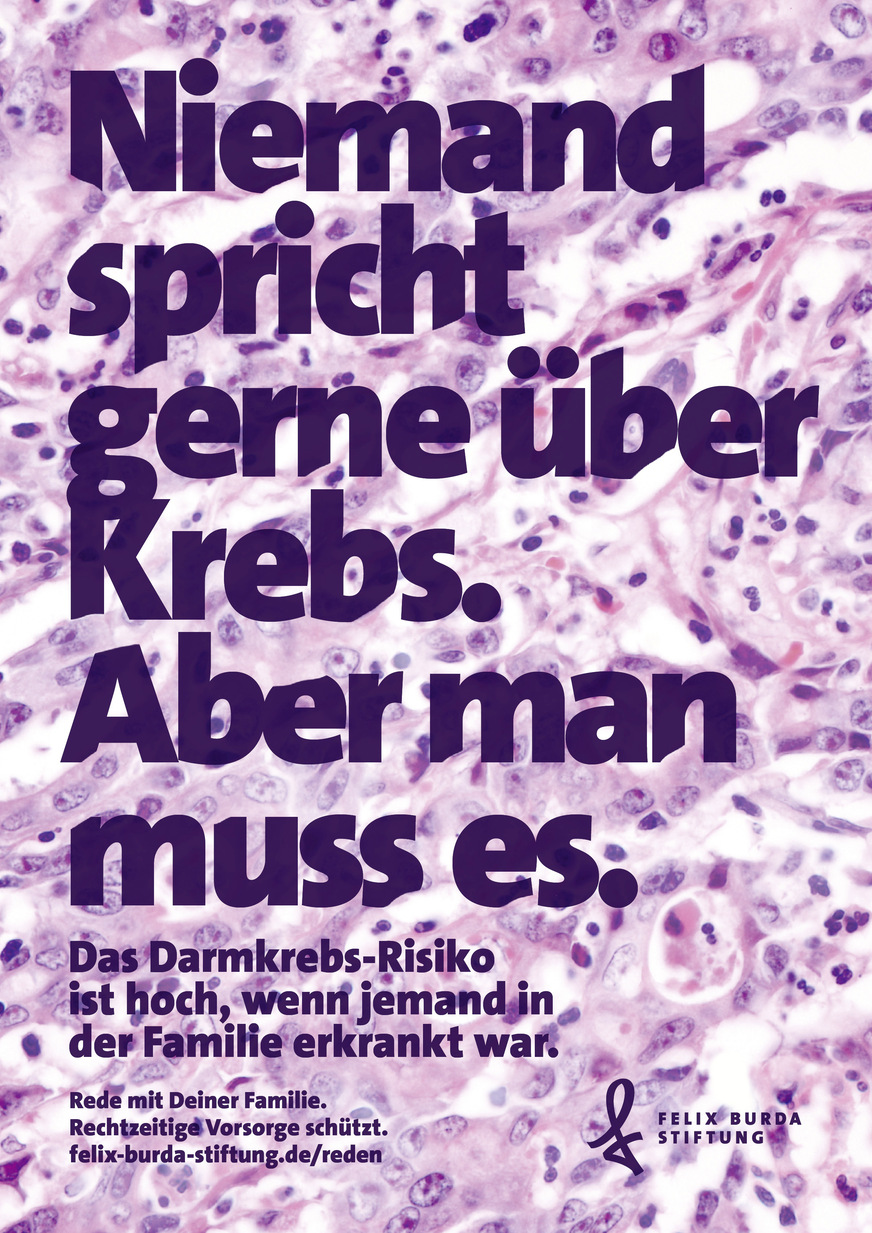

VDBW unterstützt Initiative der Felix Burda Stiftung,
der Stiftung LebensBlicke und des Netzwerks gegen
Darmkrebs e. V. im März 2020
Betriebsärzte übernehmen zentrale Rolle bei der Darmkrebsvorsorge
Darmkrebs zählt zu den drei häufigsten Tumorerkrankungen und doch gehört er zu den wenigen Krebsdiagnosen, die vermeidbar sind. Betriebsmedizinerinnen und -mediziner können entsprechende Vorsorgemaßnahmen initiieren, um Darmkrebs komplett zu verhindern oder ihn zumindest so früh zu erkennen, dass er heilbar ist. Der Verband Deutscher Betriebs- und Werksärzte e. V. (VDBW) unterstützt deshalb den Darmkrebsmonat März 2020 der Felix Burda Stiftung.
Mit dem am 9. April 2013 in Kraft getretenen Krebsfrüherkennungs- und -registergesetz (KFRG) wurden Untersuchungen zur Früherkennung von Darmkrebs gesetzlich verankert. Personen im Alter von 50 bis 54 Jahren können jährlich einen Test auf verstecktes Blut im Stuhl (FOBT) durchführen lassen. Gibt es Fälle von Darmkrebs in der Familie, sollte der Test bereits früher durchgeführt werden. Die Kosten für den FOBT-Test übernimmt die Gesetzliche Krankenkasse.
Ist das Testergebnis auffällig, sollte im nächsten Schritt mittels einer Darmspiegelung (Koloskopie) abgeklärt werden, ob es sich um Darmpolypen oder Krebs handelt. Krebsvorstufen können bei solch einem Eingriff gleich entfernt werden. Ein Tumor entsteht dann gar nicht erst.
Bei einem unauffälligen Befund können Personen ab 55 Jahren den Test auf verstecktes Blut im Rahmen der Krebsfrüherkennung alle zwei Jahren wiederholen. Alternativ können Männer ab 50 Jahren, Frauen ab 55 Jahren eine Früherkennungskoloskopie (präventive Darmspiegelung) wahrnehmen, die bei unauffälligem Befund nach zehn Jahren wiederholt werden kann.

© Felix Burda Stiftung
Früherkennung – Betriebsärzte als Initiatoren
Im Rahmen eines Betrieblichen Gesundheitsmanagements kann der betriebsärztliche Dienst ganz gezielt bei der Früherkennung unterstützen. „Betriebsärzte erreichen Mitarbeiterinnen und Mitarbeiter aus unteren sozialen Schichten, die dem Thema Prävention noch nicht so aufgeschlossen sind. Dies gilt insbesondere für männliche Mitarbeiter, die Präventionsangebote noch geringer annehmen als weibliche Mitarbeiter“, sagt Dr. Wolfgang Panter, Präsident des VDBW. Außerdem kann der Betriebsarzt im Rahmen der betrieblichen Darmkrebsvorsorge auf das familiäre Risiko aufmerksam machen und damit ganz entscheidend zur Früherkennung auch bei jüngeren Beschäftigten beitragen.
Und natürlich sensibilisieren Betriebsärztinnen und -ärzte die Beschäftigten für Risikofaktoren von Darmkrebs: Dazu zählen in erster Linie Tabakkonsum und Übergewicht, aber auch Bewegungsmangel, ballaststoffarme Ernährung sowie der Genuss von Alkohol und rotem und verarbeitetem Fleisch.
Diese Möglichkeiten haben auch kleinere Unternehmen, die mit ihrem betriebsärztlichen Dienst Aktionen planen können. Für die Unternehmen bedeutet die Darmkrebsvorsorge eine Win-Win-Situation: Wenn mehr Beschäftigte an solchen Untersuchungen teilnehmen, erkranken insgesamt weniger Menschen an Darmkrebs.
VDBW unterstützt Initiative Darmkrebsmonat März 2020
Jährlich erkranken in Deutschland mehr als 60 000 Menschen an Darmkrebs. Als Berufsverband der Arbeitsmediziner in Deutschland setzt sich der VDBW für die Prävention von Darmkrebs ein und unterstützt die Initiative „Darmkrebsmonat März 2020“ der Felix Burda Stiftung, der Stiftung LebensBlicke und des Netzwerks gegen Darmkrebs e.V. Diese jährt sich 2020 zum 19. Mal und setzt sich für die Früherkennung von Darmkrebs ein.
© Felix Burda Stiftung







